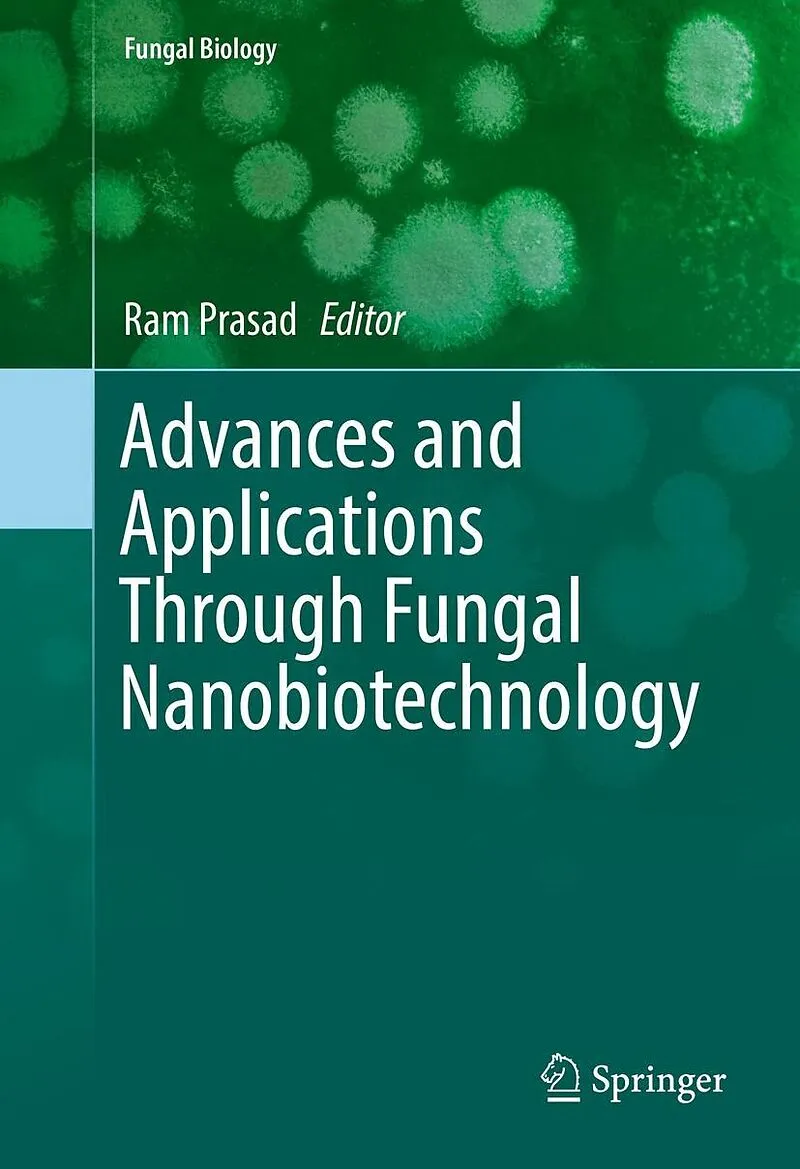

Beschreibung
Fungal nanobiotechnology has emerged as one of the key technologies, and an eco-friendly, as a source of food and harnessed to ferment and preserve foods and beverages, as well as applications in human health (antibiotics, anti-cholesterol statins, and immuno...